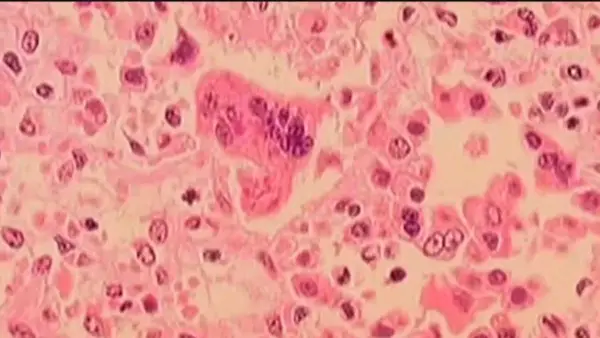
Measles Exposure Warning Issued for Boston and Westborough

Latest

US Unemployment Claims Fall to 214,000, Remain at Historically Healthy Levels
The number of Americans applying for unemployment benefits fell by 10,000 to 214,000 for the week ending December 20, according to the Labor Department. This is below the forecast of 232,000 new applications by analysts surveyed by FactSet. Despite some signs of a weakening labor market, unemployment claims remain at historically healthy levels. The weekly report was released a day early due to the Christmas holiday. Applications for unemployment aid are seen as a proxy for layoffs and are a close indicator of the job market's health. The US gained 64,000 jobs in November, but lost 105,000 in October, largely due to a drop in federal workers. The unemployment rate rose to 4.6% in November, the highest since 2021. Hiring has lost momentum, hindered by uncertainty over President Donald Trump's tariffs and the effects of high interest rates set by the Fed in 2022 and 2023. The four-week average of claims fell by 750 to 216,750, and the total number of Americans filing for jobless benefits rose by 38,000 to 1.92 million. Companies such as UPS, General Motors, Amazon, and Verizon have announced job cuts, but these reductions may take months to appear in government data. The Federal Reserve recently trimmed its benchmark lending rate, citing concerns that the job market is weaker than it appears.

Columbus Woman Threatened by Apparent ICE Agents for Following Their Vehicles
A 20-year-old Columbus woman, Jessica Lucia Villa, and her 18-year-old sister, Alexa Lucia Villa, were pulled over and threatened by individuals they believed to be ICE agents. The sisters had been following the suspicious vehicles to warn family and neighbors of a potential ICE presence in their area. The encounter, which was captured on a TikTok video, occurred on December 20 after the sisters spotted a white car and a grey SUV near a plaza on Karl Road. The agents, who were masked, approached the sisters' car and warned them to stop following them, threatening to break their window and arrest them if they continued. Villa said she had researched the legality of following law enforcement vehicles before doing so and did not believe she was doing anything wrong. The incident has sparked concern in the community, with many sharing videos of ICE arrests on social media. ICE has increased its visibility in Columbus and surrounding areas as part of "Operation Buckeye." Villa said she does not regret her actions, feeling a responsibility to protect those in her community who cannot safely leave their homes due to fear of being accosted by federal agents. Villa's decision to follow the agents was motivated by a desire to warn her family and neighbors, particularly those who are undocumented or have loved ones who are. She expressed concern for the well-being of families who are being "ripped apart" by ICE actions. The Columbus Dispatch reached out to ICE for comment on the incident, but the agency has not yet responded. Ohio law states that a person commits an offense only if they "hamper or impede a public official in the performance of the public official's lawful duties" through an affirmative act. Villa's actions have sparked a wider conversation about the presence of ICE in Columbus and the impact it has on the community. She said she would rather something happen to her than to someone who cannot defend themselves, highlighting the fear and uncertainty that many are feeling. The incident has been widely shared on social media, with many expressing outrage and concern over the actions of the apparent ICE agents. Villa's bravery in standing up for her community has been praised by many, with some calling her a hero for her actions.

Fantasy Football Week 17 Defense Rankings and Waiver Wire Advice
As the fantasy football finals approach, making informed decisions on defense is crucial. For Week 17, several defenses have favorable matchups that could significantly impact the outcome of games. The Denver Broncos, facing the Kansas City Chiefs with third-string quarterback Chris Oladokun, are a top choice, with a projected 11.5 points allowed. The New England Patriots, facing the New York Jets and their QB3 Brady Cook, are also highly ranked due to the Jets' struggles with sacks and turnovers. Other notable matchups include the Pittsburgh Steelers against the Cleveland Browns' Shedeur Sanders, who has been inconsistent, and the Detroit Lions against the Minnesota Vikings' Max Brosmer, who will start in place of the injured J.J. McCarthy. The New Orleans Saints, who had a strong defensive performance last week, face the Tennessee Titans and Cam Ward, while the Seattle Seahawks take on the Carolina Panthers and Bryce Young. Looking ahead to Week 18, teams like the Cleveland Browns against the Cincinnati Bengals, Atlanta Falcons against the New Orleans Saints, Green Bay Packers against the Minnesota Vikings, and Los Angeles Rams against the Arizona Cardinals could be good plays, depending on the final standings and which teams decide to rest their starters. The key to success in the finals will be identifying the right defensive matchups and being prepared for any last-minute changes due to injuries or playoff seeding. In terms of waiver wire pickups, the Patriots, available in 50% of leagues, and other decent defenses with good matchups, such as the Giants against the Las Vegas Raiders, are worth considering. Ultimately, the strategy should involve a mix of top-tier defenses with favorable matchups and smart waiver wire moves to maximize points in the fantasy football finals.

Sean 'Diddy' Combs Seeks Immediate Release from Prison, Appeals Conviction
Lawyers for hip-hop mogul Sean "Diddy" Combs have urged a federal appeals court in New York to order his immediate release from prison and reverse his conviction on prostitution-related charges. Combs, 56, was convicted under the Mann Act, which bans transporting people across state lines for any sexual crime, and sentenced to four years and two months in prison. His lawyers argue that the judge who sentenced him, Arun Subramanian, acted like a "thirteenth juror" and let evidence surrounding acquitted charges influence the punishment. They claim that Combs was treated harshly and that the sentence was excessive, noting that defendants typically receive less than 15 months for similar offenses. Combs was acquitted of racketeering conspiracy and sex trafficking at a trial that ended in July, but was convicted of two lesser counts of prostitution offenses. His lawyers argue that the judge's findings at sentencing, which included that Combs "coerced," "exploited," and "forced" his girlfriends to have sex, trumped the jury's verdict and led to an excessive sentence. The appeals court has not yet heard oral arguments in the case. Combs is currently incarcerated at a federal prison in New Jersey and is scheduled for release in May 2028.
Measles Exposure Warning Issued for Boston and Westborough
Massachusetts health officials have issued a warning about potential exposure to measles in Boston and Westborough. A visitor from Texas, who was infected with measles, traveled to the area on December 11 and departed on December 12. Potential exposures may have occurred at Logan Airport Terminal B, the DoubleTree by Hilton Hotel Boston-Westborough, and Logan Airport Terminal C. Symptoms of measles may resemble a cold and can appear one to three weeks after exposure, followed by a skin rash. The risk of infection is low due to the high vaccination rate in Massachusetts, but individuals who are not immune and visited these locations may be at risk. Two doses of the MMR vaccine are 97% effective in preventing measles. Anyone who may have been exposed and develops symptoms is advised to call their healthcare provider before visiting an office or emergency department.

US Denies Visas to UK Campaigners and European Officials Over Free Speech Concerns
The US State Department has denied visas to five individuals, including two British campaigners, accusing them of seeking to "coerce" American tech platforms into suppressing free speech. Imran Ahmed, head of the Centre for Countering Digital Hate (CCDH), and Clare Melford, CEO of the Global Disinformation Index (GDI), were labelled "radical activists" by the Trump administration. A French ex-EU commissioner, Thierry Breton, and two senior figures at a Germany-based anti-online hate group, Anna-Lena von Hodenberg and Josephine Ballon, were also denied visas. The move has been met with criticism from European leaders, with French President Emmanuel Macron calling it "intimidation" and the EU "strongly condemning" the visa ban. The UK government stated it is "fully committed" to upholding free speech, while also supporting laws and institutions that work to keep the internet free from harmful content. The US government billed the measures as a response to individuals and organizations that have campaigned for restrictions on American tech firms. Secretary of State Marco Rubio stated that the individuals belonged to a "global censorship-industrial complex" and that the US would not tolerate "extraterritorial overreach" by foreign censors targeting American speech. The affected individuals and organizations have denied the allegations, with the GDI calling the visa sanctions an "authoritarian attack on free speech" and the CCDH yet to comment. The move has sparked a diplomatic row between the US and European countries, with the EU seeking clarification on the visa ban.

Redistricting Battles Intensify Ahead of 2026 Midterms
The race to redistrict is escalating, with five states adopting new congressional maps since September and many lawsuits moving through courts. The effects on the midterms are increasingly unpredictable, with the Supreme Court set to rule on a major case that may gut the Voting Rights Act. Readers' questions about the landscape have been answered, including how mid-decade redistricting is constitutional, the potential gains for each party, and the role of courts in addressing complaints. The Supreme Court has ruled that neither the federal constitution nor federal law bans mid-decade redistricting, and Congress has the authority to create a prohibition. Several bills have been filed to ban states from redrawing maps mid-decade unless ordered to by a court. The current count of seats that have become more red or blue due to redistricting shows a slight overall advantage for the GOP, with one to two seats gained across six states. However, the outcome is uncertain, with two more states set to redraw their maps and the possibility of the Supreme Court gutting the Voting Rights Act. State Democrats who have control are not redistricting in some cases due to legal barriers, while in others, they are choosing not to. Some states have constitutional rules against gerrymandering, which can affect the electoral map. Utah's courts invoked such rules to strike down a GOP-drawn map, but the effectiveness of these rules depends on judges applying them. Nationwide reforms, such as independent commissions or proportional representation, could address the issue of uncompetitive districts. Proportional representation, in particular, may help third parties grow and diminish the importance of redistricting. The Supreme Court's inconsistent application of the Purcell principle has been criticized, with concerns that it may be used to game federal law. The principle, which prohibits courts from intervening in election-related cases close to an election, has been applied unevenly, leaving voters and politicians frustrated. As the redistricting landscape continues to evolve, the impact on the 2026 midterms remains uncertain, with many factors at play.

Ralph Fiennes Stars in 'The Choral,' a WWI Drama About Finding Hope Through Music
The new film "The Choral" tells the story of a northern English town that loses its best choral singers to fighting in World War I. The town finds new hope in a time of loss through music, led by Henry Guthrie, played by Ralph Fiennes, an uncompromising musician who overhauls the struggling local choir. Director Nicholas Hytner explains that music is an expression of community and a way to survive, insisting that there are ways to get through the disaster without collapsing into complete despair. The film is set in 1916, during the midst of World War I, and follows the town's choir as they recruit women and men either too young or too old to fight. They perform Edward Elgar's The Dream of Gerontius, which lifts the town's spirits. Fiennes notes that making music together can take people to another plane, and Hytner says that the story felt cinematic in structure and needed to be present in a way that only film can do. The Choral marks the fourth screen collaboration between director Hytner and writer Alan Bennett, but the first intended as a film from the start. The film began development in March 2020, and Hytner says that the First World War serves as a template for everything artists have wanted to say about what war does to us. The film features a talented cast, including Simon Russell Beale as Edward Elgar, and is a powerful exploration of the impact of war on a community and the role of music in bringing people together.

Powerball's $1.7 Billion Jackpot Up for Grabs on Christmas Eve
A Christmas Eve Powerball drawing could bring unprecedented holiday cheer, with a record $1.7 billion prize on the line. This jackpot, the fourth-largest in U.S. history, comes after 46 consecutive draws without a winner. The last jackpot winner was on September 6, and the long odds have driven interest in the game. The odds of winning are 1 in 292.2 million, which were made tougher in 2015 to create larger jackpots. Despite the low chances, millions of players are hoping to cash in on the massive prize. The winning ticket must be purchased in one of the 45 states, Washington, D.C., Puerto Rico, or the U.S. Virgin Islands, where the game is played. Players must be at least 18 years old, although some states have higher age requirements. The jackpot has a cash value of $781.3 million, and winners can choose to receive the prize through an annuity or a lump sum. While the top prize is the main attraction, there are also smaller prizes available, ranging from a few dollars to $2 million. Lottery officials are encouraging players to dream big, with the New Hampshire Lottery's executive director, Charlie McIntyre, saying, "Just think of the stories you can tell for generations to come about the year you woke up a billionaire on Christmas." With the drawing set to take place on Christmas Eve, millions of players are holding out hope that they will be the lucky winner of the massive jackpot.

Settler Rampages Against Palestinians in West Bank Increase in 2025
The year 2025 has seen a significant rise in settler rampages targeting Palestinians in the West Bank, with the Israeli Defense Forces (IDF) reporting an average of about 70 incidents per month. This increase surpasses the numbers from 2024 and previous years. Despite the escalation, the issue has garnered less attention from the majority of Israelis, who have been distracted by the ongoing war in Gaza and the opening of other fronts. The data, released by the IDF in November, highlights the growing concern of violence against Palestinians in the West Bank. The situation has been overshadowed by other conflicts, leading to a lack of awareness and attention to the increasing settler rampages. As the year comes to a close, the trend of rising violence against Palestinians in the West Bank remains a pressing issue that requires attention and action. The IDF's data serves as a reminder of the need to address the growing tensions and conflicts in the region. With the war in Gaza and other fronts dominating the headlines, it is essential to acknowledge and address the settler rampages in the West Bank to work towards a more peaceful and stable environment for all parties involved.

Samsung Galaxy Z TriFold Durability Test Shows Hinge Giving Way After 150,000 Folds
The Samsung Galaxy Z TriFold, a brand new form factor from the company, has undergone a durability test to assess its ability to withstand repeated folding and unfolding. According to Samsung, the device has been tested for 200,000 folds, which simulates 100 folds per day for 5 years. However, a YouTube channel called "OMG_electronics" conducted its own test, livestreaming the folding and unfolding process until the device showed signs of wear. The test, which took place over several days, found that the Galaxy Z TriFold's hinge started to creak after around 61,000 folds, with the second hinge following suit after 121,000 folds. At around 144,000 folds, the hinge elasticity gave way, making it difficult to open and close the device. Although the display was still functional, the device's usability was significantly impaired. Despite not reaching Samsung's promised 200,000 folds, the Galaxy Z TriFold held up relatively well considering the intense testing conditions. The device is set to launch in the US in early 2026, with a likely price tag of around $2,800.

Broncos to Face Chiefs on Christmas Day in Week 17 Matchup
The Denver Broncos will visit the Kansas City Chiefs on Christmas Day, December 25, at 6:15 p.m. MT for a prime-time matchup. The Broncos, currently holding the No. 1 seed in the AFC with a 12-3 record, aim to earn a season sweep of their division rival for the first time since 2014 and improve to 4-1 in the AFC West. A win, combined with a Chargers loss on Saturday, could clinch the AFC West as early as Week 17. The game will be nationally broadcast on Amazon Prime Video, with Al Michaels and Kirk Herbstreit providing play-by-play and analysis, respectively. Locally, the game can be watched on DENVER7, and internationally on NFL GamePass International. For radio listeners, the game will be broadcast on KOA – 850 AM/94.1 FM locally, with Dave Logan and Rick Lewis on the call, and on Westwood One Sports nationally, featuring J.P. Shadrick and Ryan Leaf. The Broncos released their second estimated injury report on Tuesday, which can be found on their official website. The team is focused on earning a crucial win, with Head Coach Sean Payton emphasizing the significance of the game with two weeks left in the season. The Broncos will wear their all-Summit White uniforms for the matchup, a first for the team.

Will Arnett Takes on Dramatic Role in "Is This Thing On?"
Will Arnett, known for his comedic roles in "Arrested Development" and "30 Rock," is taking on a more dramatic role in the upcoming film "Is This Thing On?" The movie, directed by Bradley Cooper, tells the story of a man who processes his marital separation onstage at open mic nights. Arnett was inspired by the true story of British comedian John Bishop, who used stand-up comedy to work through his emotions during a difficult time in his marriage. Arnett and writer Mark Chappell adapted Bishop's story for the film, which also stars Laura Dern as Arnett's character's wife. To prepare for the role, Arnett tried his hand at stand-up comedy, performing at Manhattan's Comedy Cellar and using the experience to inform his character's development. The film marks a departure from Arnett's typical comedic roles, showcasing his range as an actor. Cooper's direction brings a level of vulnerability and authenticity to the story, exploring the breakdown of communication in relationships. Arnett credits the film's success to the understanding that life's biggest moments often happen in mundane settings, without buildup or fanfare. With "Is This Thing On?", Arnett proves himself to be a talented dramatic actor, bringing a new level of depth to his performances.

Gaza's Christian Community Finds Joy Amidst Devastation During Christmas
In the midst of a fragile ceasefire, Gaza's tiny Christian community is trying to capture the holiday spirit despite the destruction and uncertainty surrounding them. Attallah Tarazi, a 76-year-old Palestinian Christian, received Christmas presents, including socks and a scarf, and joined fellow Christians in singing hymns. The community is clinging to hope and faith, with Tarazi saying, "I feel like our joy over Christ's birth must surpass all the bitterness that we've been through." Cardinal Pierbattista Pizzaballa, the Latin Patriarch of Jerusalem, visited the Holy Family Parish, marking the beginning of Christmas celebrations in a community that has lived through dark and challenging times. However, for some, the toll of the war is inescapable, and the absence of loved ones who fled Gaza has made Christmas feel different. Despite the struggles, some Christians are trying to bring joy to their children, with Elynour Amash decorating her home and lighting the tree to create a sense of joy amidst the pain. The community remains determined to stay and preserve their Christian presence in Gaza, with Tarazi praying for peace and freedom for the Palestinian people. The war has caused widespread destruction, displacing the vast majority of Gaza's 2 million residents, and the Christian community is worried about their presence in the territory. Many Christians have fled, and some are hoping to leave if given the opportunity, which could affect the social fabric of Gaza. Despite the challenges, the community remains steadfast in their faith, with Amash saying, "Our presence, no matter how small, is a testimony of love, steadfastness, and faith in this land."

Venezuela Accuses US of Extortion Over Seizure of Oil Tankers
Venezuela has accused the United States of "the greatest extortion" at an emergency session of the UN Security Council in New York. The accusation comes after the US seized two Venezuelan oil tankers off the coast of Venezuela earlier this month. The Venezuelan ambassador to the UN, Samuel Moncada, described the seizure as "worse than piracy" and said it was an example of the US acting outside of international law. The US has also announced that it is pursuing a third Venezuelan oil tanker and has said it will keep or sell the crude oil it has taken, as well as the vessels themselves. The US has been building up its military presence in the Pacific and Caribbean Seas in recent months, with the stated aim of stopping the flow of fentanyl and cocaine to the US. The US Ambassador to the UN, Michael Waltz, responded by saying that the US does not recognize President Nicolas Maduro as the legitimate leader of Venezuela and that his ability to sell Venezuela's oil enables his "fraudulent claims to power and his narco-terrorist activities." Russia and China have accused the US of bullying and aggression, with the Russian ambassador warning that other countries could be next. The seizure of the oil tankers is part of a larger escalation of tensions between the US and Venezuela, with President Trump having ordered a naval blockade of all sanctioned oil tankers entering and leaving Venezuela on December 16. The situation has sparked concerns about the potential for further conflict in the region.

Federal Judge Upholds New York's Green Light Law, Allowing Driver's Licenses for Undocumented Immigrants
A federal judge has ruled in favor of New York's Green Light Law, which allows undocumented immigrants to obtain driver's licenses without proving their legal status. U.S. District Judge Anne M. Nardacci rejected the Trump administration's challenge to the law, stating that the administration failed to support its claims that the law usurps federal law or discriminates against the federal government. The law, enacted to improve public safety on the roads, allows individuals without a valid Social Security number to submit alternative forms of ID, such as valid passports or driver's licenses issued in other countries. Applicants must still pass a road test to qualify for a standard driver's license. The Justice Department had argued that the law was a "frontal assault" on federal immigration laws and sought to strike it down. However, Judge Nardacci found that the administration's arguments did not establish a violation of the U.S. Constitution's Supremacy Clause. The ruling allows New York to continue issuing driver's licenses to undocumented immigrants, making it easier for them to obtain auto insurance and reducing the number of uninsured drivers on the road. The decision is a significant victory for the state and immigrant advocacy groups, who have argued that the law is essential for public safety and the well-being of immigrant communities. The Green Light Law has been the subject of controversy since its enactment, with the Trump administration attempting to pressure New York into changing the law by restricting access to trusted traveler programs. However, the state has maintained that the law is essential for improving public safety and promoting the integration of immigrant communities. With Judge Nardacci's ruling, the law will remain in effect, allowing thousands of undocumented immigrants to obtain driver's licenses and access other essential services.

NORAD Celebrates 70 Years of Tracking Santa's Sleigh
The North American Aerospace Defense Command (NORAD) is celebrating 70 years of tracking Santa's sleigh. The tradition began in 1955 when a child accidentally called Colonel Harry Shoup of Continental Air Defense Command (CONAD) instead of Santa Claus. Shoup recognized the opportunity to use the interest in Santa to call attention to the air defense system. A few weeks after the call, Shoup informed the news wire services that CONAD was tracking Santa's sleigh, and the story was well-received by reporters. In 1957, Canada and the U.S. formed the North American Air Defense Command, which later became NORAD. By Christmas Eve 1960, NORAD was posting updates on Santa's flight, including a reported emergency landing on the ice of Hudson Bay. Since then, NORAD has continued to track Santa's sleigh, with fighter jets frequently intercepting the sleigh to salute Santa. The operation has grown to include over 1,000 Canadian and American military personnel, Defense Department civilian workers, and local participants who volunteer to answer over 100,000 phone calls from children around the world on Christmas Eve. The tradition has become a testament to the longstanding U.S.-Canadian friendship and a way for adults to create a magical world for children. For one night a year, the world of international alliances, intelligence, radar, satellites, and fighter jets turns into a night of magic and wonder. NORAD's mission has expanded over the years to include collecting information about the Earth's atmosphere, coastal waters, and intelligence, and it remains key to U.S. and Canadian defense. The tradition of tracking Santa's sleigh has become an integral part of NORAD's operations and a beloved holiday tradition for children around the world.

19 States and D.C. Sue HHS Over Effort to Ban Transgender Care for Minors
A coalition of 19 states and the District of Columbia has sued the U.S. Department of Health and Human Services (HHS) over a declaration that could limit access to gender-affirming care for young people. The declaration, issued last Thursday, deemed treatments like puberty blockers, hormone therapy, and surgeries unsafe and ineffective for children and adolescents experiencing gender dysphoria. It also warned doctors that they could be excluded from federal health programs if they provide such care. The lawsuit, filed in U.S. District Court in Eugene, Oregon, alleges that the declaration is inaccurate and unlawful. It claims that HHS's declaration seeks to coerce providers to stop providing gender-affirming care and circumvent legal requirements for policy changes. New York Attorney General Letitia James, who led the lawsuit, stated that Secretary Robert F. Kennedy Jr. cannot unilaterally change medical standards and that no one should lose access to medically necessary healthcare due to government interference. The declaration is part of a broader effort by the Trump administration to limit gender-affirming healthcare for children and teenagers. HHS has also proposed rules to cut off federal Medicaid and Medicare funding from hospitals that provide gender-affirming care to children. Major medical groups and organizations have criticized the report as inaccurate, and most major U.S. medical organizations continue to oppose restrictions on transgender care and services for young people. The lawsuit was joined by Democratic attorneys general from 18 states and the District of Columbia, as well as Pennsylvania's Democratic governor. The case marks the latest clash between the administration and advocates for transgender healthcare, with the administration arguing that such care can be harmful to children and advocates saying it is medically necessary and should not be inhibited.

Biological Computationalism Offers New Perspective on Consciousness
The debate about consciousness is often polarized between computational functionalism and biological naturalism. However, a new concept, biological computationalism, proposes a third path to understanding consciousness. This idea suggests that computation in the brain is unique and cannot be fully explained by traditional computational paradigms. Biological computationalism has three defining properties: it is hybrid, combining discrete events with continuous dynamics; scale-inseparable, with no clear distinction between software and hardware; and metabolically grounded, with energy constraints shaping computation. This perspective implies that consciousness depends on computation deeply integrated with physical and energetic constraints. As a result, replicating mind-like cognition may require new physical systems beyond conventional digital architectures. The brain's computation is not just a matter of abstract symbol manipulation, but an intrinsic property of the system itself, shaped by its physical organization and energetic constraints. This challenges the current approach to artificial intelligence, which focuses on improving algorithms rather than the underlying computational ontology. Biological computationalism demands a shift from searching for the right program to searching for the right kind of computing matter, one that is hybrid, scale-inseparable, and energetically grounded.

US Delays Tariffs on China's Chip Industry Until 2027
The Trump administration has concluded that China's policies to dominate the semiconductor industry are unfair and will impose tariffs, but the implementation will be delayed until June 23, 2027. A year-long investigation by the US Trade Representative (USTR) found that China's targeting of semiconductors is "unreasonable and burdens or restricts US commerce." The investigation, undertaken through Section 301 of the Trade Act of 1974, determined that China has employed aggressive and non-market policies to achieve dominance in the sector. The USTR probe found that China's policies have included massive and persistent state support of private actors and wage-suppressing labor practices. The current tariff level of zero will be increased to a rate to be announced not fewer than 30 days prior to the implementation date. Beijing has opposed the move, accusing Washington of abusing tariffs to suppress Chinese industries and disrupting the global supply chain. The decision to delay the tariffs for 18 months was not explained by the USTR. The Trump administration has been known to use tariffs as a policy tool, imposing levies on steel, autos, and other items. The US and China had previously reached a broad truce after a major escalation in the spring. The delayed tariffs are seen as a significant development in the ongoing trade tensions between the two countries.